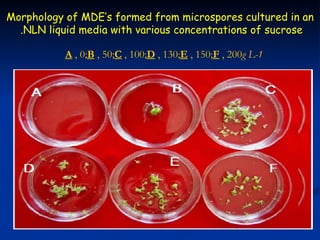
Morphology of MDE‘s formed from microspores cultured in an
  .NLN liquid media with various concentrations of sucrose

           A , 0;B , 50;C , 100;D , 130;E , 150;F , 200g L-1

This study investigated factors affecting microspore-derived embryo formation in broccoli. The results showed that a 0.5X strength NLN liquid medium with 13% sucrose and a 24 hour heat shock treatment at 32.5°C produced the highest microspore-derived embryo yields. Higher concentrations of nutrients or sucrose inhibited embryo formation, while lower concentrations did not support microspore survival and division. These parameters provide an optimized protocol for microspore culture in broccoli.